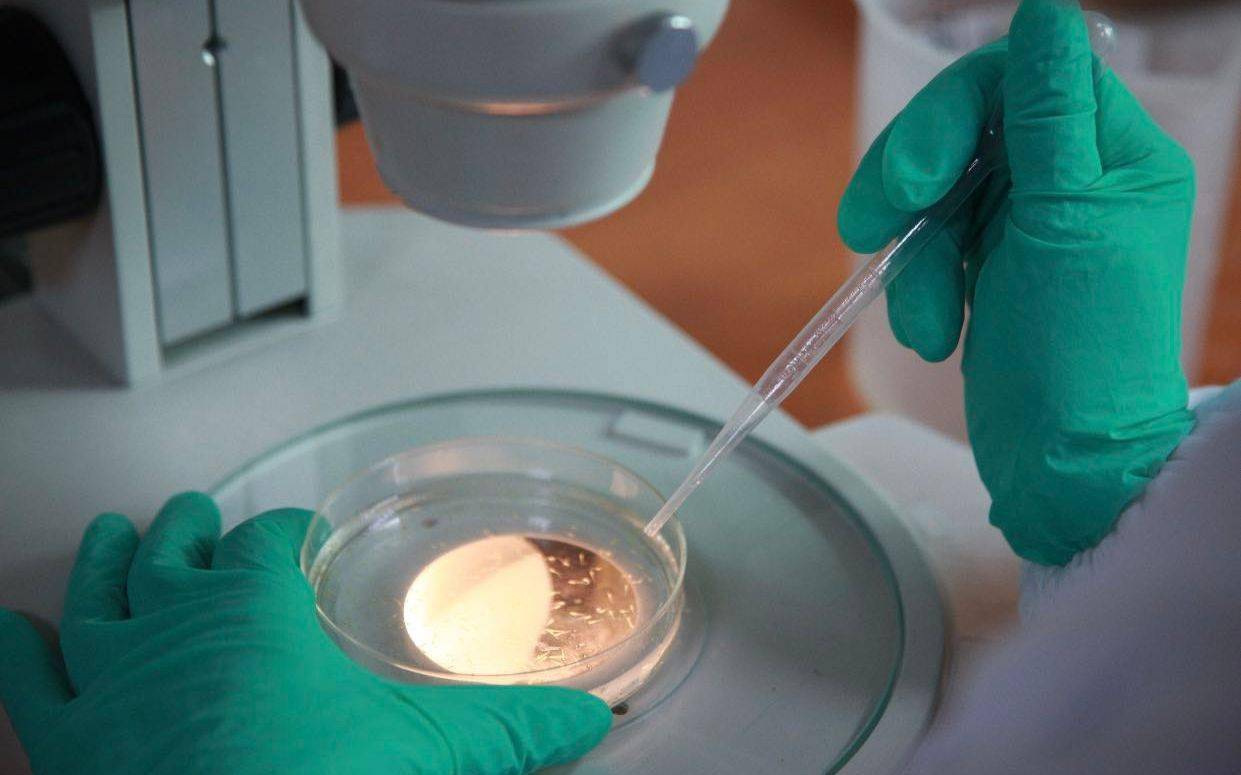
评价|无限极解锁新技术：“水中小白鼠”斑马鱼将用于筛选保健品

评价|无限极解锁新技术:“水中小白鼠”斑马鱼将用于筛选保健品
_原题为 无限极解锁新技术:“水中小白鼠”斑马鱼将用于筛选保健品
新京报讯(采访人员 王卡拉)“水中小白鼠”斑马鱼将在筛选营养保健产品领域大展身手 。 7月23日 , 无限极透露 , 中国食品科学技术学会近日在京组织有关专家对无限极(中国)有限公司联合杭州环特生物科技股份有限公司共同研发的“斑马鱼功效与安全性快速评价系统在健康食品中的应用”项目进行成果评价 。
与会专家一致认为 , 该项目建立的斑马鱼功效与安全性快速评价系统 , 是对现有哺乳动物模型功效及安全性评价方法的有效补充 , 将有效提升健康食品原料端质量把控 , 推动健康产品行业发展 。
斑马鱼和人类基因有着87%的高度同源性

文章图片
“对于企业来说 , 哪种保健食品原料能用 , 哪种不能用 , 需要建立一种快速、有效的检测方法系统 。 ”无限极(中国)质量保证总监刘凤松阐述建立保健品生物评估模型的原因所在时介绍 , 利用斑马鱼安全性评价方法 , 研发团队建立包含112种食品原料和44款产品安全性数据的产品原料斑马鱼安全性评价数据库 , 为配方筛选、产品优化、质量控制等提供了技术方法 。
斑马鱼生理、发育和代谢与哺乳类动物高度相似 , 和人类基因有着87%的高度同源性 , 包括癌症在内的约2000种人类疾病能出现在斑马鱼身上 。 因为能可靠模拟和预测人类生理、病理过程 , 此项技术目前已广泛应用于药物安全性评价领域 , 对国内保健食品领域来说属于一项创新尝试 。
事实上 , 早在2003年 , 美国国立卫生研究院(NIH)就将斑马鱼列为重要的实验生物 , 仅次于大鼠(Rat)和小鼠(Mouse) 。 2009年 , 位于阿肯色州的美国国家毒理学研究中心(NCTR)设立斑马鱼实验室 , 开始用斑马鱼的胚胎和幼鱼 , 展开药物和化学物质对器官和系统的影响等研究 。
在项目评估会上 , 中国工程院院士、北京工商大学校长孙宝国表示 , 项目团队做了一个开创性工作 。 一方面 , 首次在国内将斑马鱼模型应用于以保健食品功能和安全性评价及原料筛选;另一方面 , 建立了相应的团体标准 。
【评价|无限极解锁新技术:“水中小白鼠”斑马鱼将用于筛选保健品】中国工程院院士、广东省微生物研究所研究员吴清平对国内企业的这种创新尝试表示认可 。 他表示 , 无限极率先将斑马鱼模型引入功能食品的安全性和功能性评价系统 , 体现了行业龙头企业的担当精神 。
《保健食品润肠通便功能的斑马鱼检测方法》和《保健食品抗氧化功能的斑马鱼检测方法》两项团体标准将于2020年8月1日起正式实施 , 两项标准由环特生物和无限极在内的11家生物保健品企业合作共同起草 , 为保健食品新规下的产品配方研发、原料筛选以及已上市保健食品功能验证 , 提供全新的补充检测方法 , 填补了我国保健食品相关检测技术研究领域的空白 。
斑马鱼技术帮助直观检测产品功效和安全性
文章图片
相比实验室小白鼠 , 斑马鱼有着观察条件佳、测试成本低、培育周期短的优点 。 以润肠通便测试为例 , 传统的小白鼠实验周期较长 , 实验结果受主观因素干扰大 , 而斑马鱼实验 , 能非常直观地评价受试物对斑马鱼肠道内食物排泄的促进作用 。
斑马鱼的实验方式更为直观 , 这也使得在斑马鱼身上完成建立评价模型、给予样品处理、收集测试结果等流程 , 仅需要一周左右的时间 。 对于其他动物模型来说 , 该流程至少需要数月才能完成 。
因为鱼胚胎对于急性、慢性等有害毒素非常敏感 , 鱼胚胎生物测试技术可以更加快速和全面地测定原料及产品的整体安全性 。 作为健康产业代表企业之一 , 无限极近年来也开始探索鱼胚胎生物测试技术在保健食品上的应用 。
2018年 , 无限极携手生物科技公司水中银组建鱼胚胎生物安全评估合作平台 , 将鱼胚胎生物毒性测试技术应用于健康食品、化妆品的原料筛选、产品毒性检查、过程控制及安全解决方案研究等领域 , 为无限极产品安全研究提供更有力的支持 。
如今 , 无限极与斑马鱼生物科技领域领先的解决方案提供商环特生物合作 , 开展“斑马鱼功效与安全性快速评价系统在健康食品中的应用”项目 , 可以说是无限极通过生物测试搭建产品安全性的进一步探索 。
近年来 , 无限极持续进行食品安全研究技术的积累和提升 。 2018年底 , 无限极联合多家单位申报“保健食品风险评估及功能评价基础研究(2018YFC1602100)”项目 。 在该项目中 , 无限极承担研究保健食品内、外源风险物质 , 生产过程风险物质识别及预警等技术的主要研发任务 , 针对原材料、生产过程风险因素进行识别、降低和消除 。 该项目获得2018年度国家重点研发计划“食品安全关键技术研发”专项立项 。
为保障从源头开始的产品安全 , 无限极多年来始终坚守“100-1=0”——“质量管理零缺陷、产品安全零容忍、质量服务零距离”的质量理念 , 从源头坚持选用高品质原料到生产环节多项高标准的安全检测 , 运用现代化技术保障产品质量安全 。
推荐阅读
- 媒体播放器|无人拯救暴风
- 1298元购买民宿年卡能无限次住 是坑还是赚?
- 时政|2019年度全省营商环境评价结果发布 平均得分比上年提升9.59分
- 鹤壁|2019年河南营商环境评价“成绩单”发榜 郑州、洛阳、鹤壁位列前三
- 论文|中科大学术委员会回应“情侣送礼研究”博士论文:不评价好坏
- 评价|青你2虞书欣不穿塑身衣学舞,听清Lisa的评价,欣欣子要哭
- 中国抗疫医疗专家组圆满完成在南苏丹工作 受到各界高度评价
- 生态环境部上线环境影响评价信用平台|生态环境部上线环境影响评价信用平台 对环评文件弄虚作假零容忍
- 调查|调查|一年无限次住的民宿卡,是坑还是赚?她花1298元买卡之后……
- 音乐|腾讯音乐娱乐集团“新赏”特别企划发布 探索音乐内容创造无限可能

![[岁月廷湖]南美巴铁开辟秘密航线,抢运大批国产N95口罩,严防被美国截胡](https://imgcdn.toutiaoyule.com/20200420/20200420072543150661a_t.jpeg)













